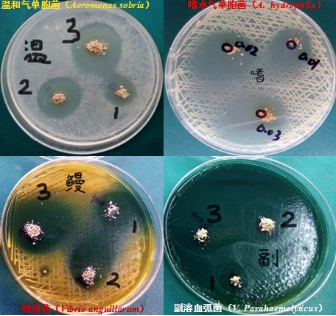
6401.png

NEWS
美瑞泰科合作伙伴参展印度国际水产展览会
发布时间:2022-04-08作者:来源:浏览次数:6380
2022年4月6-8日,正值国内新冠病毒疫情肆虐之际,美瑞泰科公司在亚太区的合作伙伴与印度经销公司一起,顺利参加了在印度Chennai举办的“国际水产大会与展览会”。

美瑞泰科此次参展的产品是公司欧洲进口的止痢草提取物(Origanum vulgare hirtum)为基础原料的旗舰产品--PHYTOGEN-AQUA(好力高-水产专用),具有很强的杀菌抑菌及抗氧化功能,水便稀便绿便的克星,对预防水产动物与畜禽消化道细菌性疾病大肠杆菌、沙门氏菌和金黄色葡萄球菌最为有效,也可防治球虫病。尤其对虾哈维氏弧菌、副溶血弧菌、创伤弧菌等感染。另外,止痢草提取物在虾养殖中预防白便和治疗白便最为有效。

作为国内最早(2000年)获得农业部植物提取物产品进口批文的领先公司,我们始终如一坚持科技领先,目前PHYTOGEN(好力高)产品已经在加拿大,印度,韩国,台湾和东南亚等国家与地区注册批准使用,受到众多用户的好评。
下一篇:春暖三月,最美她力量!
上一篇:夏季热应激的危害及解决方案
标签:
